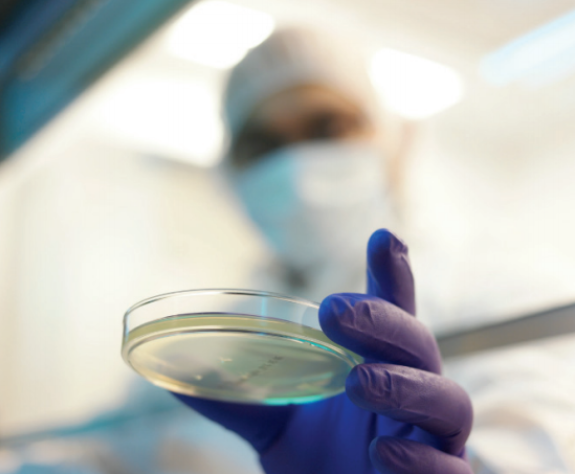
QQ20241126-141240.png

持續(xù)可行的監(jiān)測在無菌生產中至關重要,特別是在2022年制定的歐盟GMP附件1指南下。這些指南強調在A級地區(qū)進行實時環(huán)境監(jiān)測,以快速識別和解決污染風險。通過使用較低的流速,如10L/min ActiveCount遠程空氣采樣器,您可以顯著增強監(jiān)測過程,同時實現成本效益。較低的流速會更少的使用取樣板,從而減少了培養(yǎng)基的消耗,并最大限度地減少了培養(yǎng)和處理樣品所需的勞動力。這種方法不僅符合附件1的指示,即盡量減少人為干預,而且降低了與操作員在關鍵區(qū)域的存在相關的污染風險。此外,實施較低的流速可以簡化數據管理,使您的質量保證團隊能夠專注于實時結果,而不是大量的報告。通過采用這種方法,您不僅可以確保遵守監(jiān)管標準,還可以通過減少整體資源消耗來促進環(huán)境可持續(xù)性。因此,較低的流速采樣支持有效的污染控制,同時提高了操作效率,使其成為保持制藥生產中無菌環(huán)境完整性的實用解決方案。

歐盟GMP附錄1微生物連續(xù)監(jiān)測
歐盟GMP附件1:2022非常重視無菌生產中的持續(xù)環(huán)境監(jiān)測(EM),特別是在A級環(huán)境中。該指南旨在通過確保持續(xù)實時監(jiān)測包括微生物和顆粒物計數在內的環(huán)境條件,確保立即檢測到任何偏差,從而降低污染風險。這種方法通過快速應對生產過程中可能出現的任何不利條件來加強污染控制。如本研究所驗證的,微生物空氣采樣的較低流速支持附件1的連續(xù)監(jiān)測模型,在降低操作復雜性和相關成本方面提供了實際好處。

如ActiveCount遠程空氣采樣器所示,在較低流速(10L/min)下進行連續(xù)監(jiān)測,可提供符合附件1原則的多種效率。該指南建議使用能夠最大限度地減少環(huán)境和運營影響的系統,不僅可以降低污染風險,還可以降低整體資源消耗。較低的流速允許更少的取樣板,減少了保持合規(guī)監(jiān)測所需的樣品頻率和體積,這帶來了幾個優(yōu)點:
由于連續(xù)監(jiān)測所需的TSA牌照減少,運營成本顯著降低。附件1強調在無菌環(huán)境中優(yōu)化資源,通過使用較低的流速,該設施可以通過避免過高的采樣頻率來減少介質消耗。這直接轉化為以下方面的節(jié)省:
?勞動力成本:較低的培養(yǎng)基使用量意味著培養(yǎng)板、處理結果和準備報告所花費的時間更少。?孵化和儲存資源:樣本減少意味著孵化所需的空間和能量減少,這是空間和資源稀缺的高通量設施的一個重要方面。?報告生成和數據管理:使用更少的板,可以簡化編譯、審查和存儲微生物監(jiān)測數據的過程,減少工作量,更有效地分配資源。
2.盡量減少操作員干預,降低污染風險
在較低流速下進行持續(xù)監(jiān)測也符合附件1對盡量減少無菌過程中人為干預的強調。每個操作員進入a級環(huán)境都會帶來潛在的污染風險。通過減少介質更換和樣品轉移的需要,較低的流速降低了關鍵區(qū)域對操作員在場的需求,從而保持了環(huán)境的無菌完整性。?附件1第9.28節(jié)規(guī)定“應盡量減少人為干預”,并指出無菌區(qū)的任何活動都會增加污染風險。較低的流速采樣通過減少操作員的操作和干預頻率來支持這一要求。
3.提高效率和環(huán)境可持續(xù)性
減少對大容量空氣采樣的需求與附件1鼓勵有效利用資源相一致,通過減少介質和能源消耗來支持環(huán)境可持續(xù)性。較低的流速采樣降低了暖通空調系統的負擔,通過降低支持A級和B級環(huán)境空氣質量的空氣處理機組(AHU)的能耗,符合附件關于可持續(xù)潔凈室實踐的指導。
操作示例:低流速的連續(xù)監(jiān)測工作流程
通過實施較低的流量監(jiān)測,設施可以運行一個既經濟高效又符合附件1的簡化工作流程:?采樣頻率:10 L/min采樣器允許在不頻繁更換極板的情況下進行長時間監(jiān)測。這種方法滿足了附件1的持續(xù)監(jiān)測要求,同時減少了操作員的暴露和媒體消耗。?數據審查和報告:由于需要管理的樣本較少,QA團隊可以專注于關鍵樣本的實時數據,降低總體報告要求,并允許快速識別任何微生物偏差。?系統設置和維護:較低流速的取樣器需要較少的維修和校準,這簡化了維護計劃,并確保符合附件1第5.12節(jié)的要求,該節(jié)要求對監(jiān)測設備進行定期鑒定和維護。
將低流速取樣與歐盟GMP附件1對齊
如本研究所驗證的,連續(xù)微生物監(jiān)測的較低流速在無菌制造中具有明顯的優(yōu)勢。通過減少介質和資源需求,最大限度地減少操作員干預,并與歐盟GMP附件1的環(huán)境目標保持一致,這些采樣器為潔凈室環(huán)境中的實時微生物監(jiān)測提供了一種合規(guī)且經濟高效的解決方案。因此,較低的流速采樣增強了污染控制,同時支持符合歐盟GMP標準的運營效率和可持續(xù)性,為簡化、合規(guī)和對環(huán)境負責的無菌生產實踐奠定了基礎。